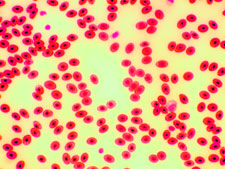
Frog blood 400x

|
The anodized aluminum piece at the left is the same that was placed under the metallurgical microscope and photographed with the DK3000 digital camera. (See images above). |
|
|
Scratched stainless steel, 100x
|
Scratched stainless steel, 200x
|
Scratched stainless steel, 400x
|
 |
This old kitchen knife was used to capture the scratched stainless steel photos above. The metallurgical microscope provided both good magnification and illumination to capture images with the DK3000 digital camera. |
|
 |
This plastic strap was originally used to keep the outside of a packing box closed. It was used under the metallurgical microscope to capture the images above. |
|